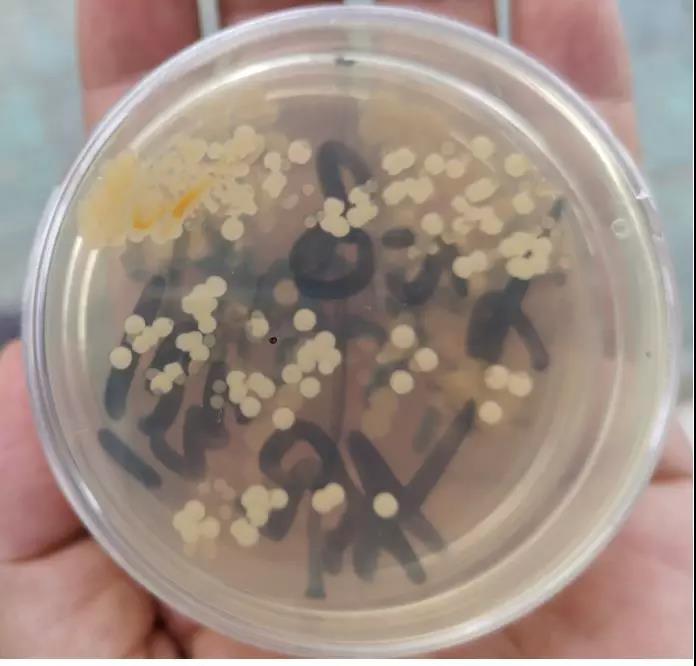
河蟹死了如何保鲜,河蟹养殖倒藻怎么办呢

每年河蟹养殖到后期常见死蟹现象,少量死蟹影响不大、也容易控制,如果出现较大的伤亡,很难控制,容易导致产量降低、严重影响经济效益,造成较大损失。造成死蟹的原因很多,主要考虑河蟹体质、池塘环境和传染病三大因素对河蟹发病的影响,我们通过以下几点来减少发病。
1、增强河蟹体质
河蟹经过高温恶劣天气的洗礼,一些池塘使用刺激*药性**物(杀蓝藻药、二氧化氯、过硫酸氢钾等)造成河蟹体质弱。此时应减少使用刺激性产品,适当补充“活力钙”(3亩/包)、“激活”(2亩/包)等增强河蟹体质。
2、改善蟹塘环境
适当拉掉池塘多余的水草,沟中伊乐藻可以全部拉掉,田面上水韭菜适当割草头保持通风,避免水草腐烂,破坏水质、耗氧;定期(7-10天)“底居安”(2亩/斤)、“底加氧”(3亩/斤)改底,减少腐烂的水草、青苔、残饵粪便等对蟹塘底层的污染,保持蟹塘较高的溶氧;有增氧机的正确使用增氧机(晴天中午12:00至下午2:00,晚上10:00开启到第二天早上6:00),可以适当过水;外河水源差、塘里蓝藻多的池塘,加强“碧水安”(1.5亩/斤)解毒频率,减少毒素对河蟹的影响。
3、控制传染病
养殖后期随着环境污染加重,普通条件致病菌繁殖较快,定期7-10天“优肽”(3亩/瓶)杀菌抑菌一次。套养青虾、龙虾的蟹塘一般密度大、污染较重,更容易滋生致病菌,要增加消毒频率,控制病原数量。后期投喂冰鲜鱼较多,容易引起肠炎,喂冰鲜鱼可以拌“冰鲜宝”(200-300斤鱼/包)减少肠炎发病率。
河蟹体内分离出致病菌
蟹塘已经出现死蟹现象,如何处理:
1、少量死蟹 主要是体质差和细菌感染引起,定期7-10天使用一次“优肽”(3亩/瓶)+“活力钙”(3亩/包)。如果软壳死蟹较多,主要是体质差引起的,可以连续使用两次(隔天用一次)“激活”(2亩/包)+“活力钙”(3亩/包)。
2、大量死蟹 特别是套养青虾或者小龙虾的蟹塘,很可能是螺原体感染或者白斑病毒感染。经过确诊后连续两次(隔天使用一次)外泼“银翘板蓝根散”(2亩/包)+“激活”(2亩/包)控制螺原体、白斑病毒的传染,增强河蟹体质,“碧水安”(1.5亩/斤)+“底居安”(2亩/斤)改善水质、底质环境。

大量死蟹

检测出螺原体
总之,河蟹养殖疾病防重于治,一旦发病就比较难处理。蟹塘发病是河蟹体质、蟹塘环境和传染病原共同作用的结果,在处理河蟹发病的时候也要全面考虑,不能只考虑单一因素,否则治疗效果较差。(出处:利洋水产)